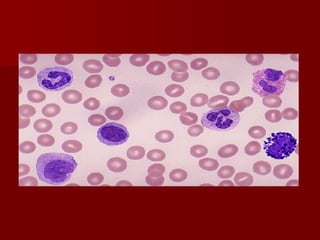

The document discusses the anatomy and physiology of the cardiovascular system, including the heart structure and function, blood vessels, conducting system, heart sounds, blood pressure regulation, and various diagnostic tests used to evaluate the cardiovascular system such as ECG, echocardiogram, stress test, cardiac catheterization, and CVP measurement. Laboratory tests discussed include cardiac enzymes, lipids, and diagnostic procedures for assessing the cardiovascular system.